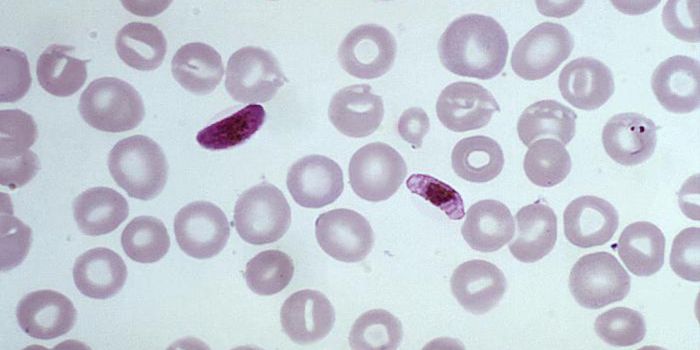
Malaria Parasite Seems to be Evolving to Evade Diagnostic Tests

Universe
The universe contains all of space, time, matter, and energy. The observable universe measures approximately 93 billion light-years in diameter today, although the size of the entire universe remains unknown.
-
OCT 07, 2021ImmunologyEven the bravest souls can get a little nervous when it comes to rolling up their sleeves and getting a shot. Aichmophob ...Written By: Tara FernandesOCT 07, 2021NeuroscienceA drug commonly prescribed for constipation shows promise for memory and cognitionOCT 07, 2021Cell & Molecular BiologyWhen cancer is diagnosed, a sample has to be taken from a patient, treated, and analyzed. Researchers have now modified ...Written By: Carmen LeitchOCT 06, 2021Chemistry & PhysicsHistorians may have found the earliest manuscripts that tell the story of Merlin the Magician. Merlin is a character fro ...Written By: Hannah DanielOCT 06, 2021Genetics & GenomicsHuntington's disease is a neurodegenerative disorder that's caused by mutations in the huntingtin gene. People can be di ...Written By: Carmen LeitchOCT 06, 2021Chemistry & PhysicsThe 2021 lineup for one of the world’s most prestigious awards has been announced, and the medal for physics has b ...Written By: Matthew LundyOCT 06, 2021TechnologyAntibiotics are the cornerstone of treatment for bacterial infections. Though antibiotic resistance caused by the incorr ...Written By: Ryan VingumOCT 06, 2021Plants & AnimalsLate last year, researchers reported the discovery of an unusual dinosaur fossil called Ubirajara in Brazil / Artwork © ...Written By: Carmen LeitchOCT 06, 2021Earth & The EnvironmentWith more people looking to reduce the amount of meat they consume, vegetable substitutes for meat are on the rise. Thou ...Written By: Samantha LottOCT 05, 2021NeuroscienceWhat you think about during idle time may contain essential indicators of your mental health. The corresponding study wa ...Written By: Annie LennonOCT 05, 2021TechnologyAccording to the Centers for Disease Control, someone in the U.S. has a heart attack about every 40 seconds. Despite bei ...Written By: Ryan VingumOCT 05, 2021ImmunologyMonths after COVID symptoms have subsided, some individuals continue to grapple with the lingering effects of the infect ...Written By: Tara FernandesOCT 05, 2021Space & AstronomyScientists were mystified by images obtained from Atacama Large Millimeter/submillimeter Array (ALMA) telescope, which s ...Written By: Carmen LeitchOCT 05, 2021MicrobiologyAntibiotic resistance is seen as a growing threat to public health, and scientists have been trying to develop new antib ...Written By: Carmen LeitchOCT 05, 2021ImmunologyMany of the deadly viruses that affect humans—including Ebola and HIV—have animal origins. These infectious ...Written By: Tara FernandesOCT 05, 2021Genetics & GenomicsAs our body ages, cells have to divide to replenish those that become worn out or damaged. Most cells also carry the gen ...Written By: Carmen LeitchOCT 04, 2021Cell & Molecular BiologyNeurons signal to one another at crucial junctions called synapses, and synaptic dysfunction is thought to play a role i ...Written By: Carmen LeitchOCT 04, 2021Genetics & GenomicsSince it's become quick and relatively inexpensive to sequence a human genome, researchers have gained unprecedented and ...Written By: Carmen LeitchOCT 03, 2021Health & MedicineWhile Dr. Anthony Fauci of NIAID is already stressing that people should still get vaccinated to help reduce COVID-19 in ...Written By: Carmen LeitchOCT 03, 2021Cell & Molecular BiologyOrganisms follow the cycle of the day, even at the cellular level, creating an internal clock. Humans' biology will ...Written By: Carmen LeitchOCT 02, 2021Genetics & GenomicsReporting in Nature Communications, scientists have suggested that every living snake on earth evolved from just a handf ...Written By: Carmen LeitchSEP 30, 2021MicrobiologyWhen health officials are trying to control a disease outbreak, diagnostic tests can be a crucial tool that provides inf ...Written By: Carmen LeitchSEP 30, 2021Clinical & Molecular DXSchematic illustration of the adhesive patch with diving beetle–inspired suction chambers against rough and wet hu ...Written By: Tara FernandesSEP 30, 2021Clinical & Molecular DXAt nine months old, most babies have started moving around independently and are curiously exploring the exciting new wo ...Written By: Tara Fernandes
OCT 07, 2021
Immunology
Even the bravest souls can get a little nervous when it comes to rolling up their sleeves and getting a shot. Aichmophob
...
Written By:
Tara Fernandes
OCT 07, 2021
Neuroscience
A drug commonly prescribed for constipation shows promise for memory and cognition
OCT 07, 2021
Cell & Molecular Biology
When cancer is diagnosed, a sample has to be taken from a patient, treated, and analyzed. Researchers have now modified
...
Written By:
Carmen Leitch
OCT 06, 2021
Chemistry & Physics
Historians may have found the earliest manuscripts that tell the story of Merlin the Magician. Merlin is a character fro
...
Written By:
Hannah Daniel
OCT 06, 2021
Genetics & Genomics
Huntington's disease is a neurodegenerative disorder that's caused by mutations in the huntingtin gene. People can be di
...
Written By:
Carmen Leitch
OCT 06, 2021
Chemistry & Physics
The 2021 lineup for one of the world’s most prestigious awards has been announced, and the medal for physics has b
...
Written By:
Matthew Lundy
OCT 06, 2021
Technology
Antibiotics are the cornerstone of treatment for bacterial infections. Though antibiotic resistance caused by the incorr
...
Written By:
Ryan Vingum
OCT 06, 2021
Plants & Animals
Late last year, researchers reported the discovery of an unusual dinosaur fossil called Ubirajara in Brazil / Artwork ©
...
Written By:
Carmen Leitch
OCT 06, 2021
Earth & The Environment
With more people looking to reduce the amount of meat they consume, vegetable substitutes for meat are on the rise. Thou
...
Written By:
Samantha Lott
OCT 05, 2021
Neuroscience
What you think about during idle time may contain essential indicators of your mental health. The corresponding study wa
...
Written By:
Annie Lennon
OCT 05, 2021
Technology
According to the Centers for Disease Control, someone in the U.S. has a heart attack about every 40 seconds. Despite bei
...
Written By:
Ryan Vingum
OCT 05, 2021
Immunology
Months after COVID symptoms have subsided, some individuals continue to grapple with the lingering effects of the infect
...
Written By:
Tara Fernandes
OCT 05, 2021
Space & Astronomy
Scientists were mystified by images obtained from Atacama Large Millimeter/submillimeter Array (ALMA) telescope, which s
...
Written By:
Carmen Leitch
OCT 05, 2021
Microbiology
Antibiotic resistance is seen as a growing threat to public health, and scientists have been trying to develop new antib
...
Written By:
Carmen Leitch
OCT 05, 2021
Immunology
Many of the deadly viruses that affect humans—including Ebola and HIV—have animal origins. These infectious
...
Written By:
Tara Fernandes
OCT 05, 2021
Genetics & Genomics
As our body ages, cells have to divide to replenish those that become worn out or damaged. Most cells also carry the gen
...
Written By:
Carmen Leitch
OCT 04, 2021
Cell & Molecular Biology
Neurons signal to one another at crucial junctions called synapses, and synaptic dysfunction is thought to play a role i
...
Written By:
Carmen Leitch
OCT 04, 2021
Genetics & Genomics
Since it's become quick and relatively inexpensive to sequence a human genome, researchers have gained unprecedented and
...
Written By:
Carmen Leitch
OCT 03, 2021
Health & Medicine
While Dr. Anthony Fauci of NIAID is already stressing that people should still get vaccinated to help reduce COVID-19 in
...
Written By:
Carmen Leitch
OCT 03, 2021
Cell & Molecular Biology
Organisms follow the cycle of the day, even at the cellular level, creating an internal clock. Humans' biology will
...
Written By:
Carmen Leitch
OCT 02, 2021
Genetics & Genomics
Reporting in Nature Communications, scientists have suggested that every living snake on earth evolved from just a handf
...
Written By:
Carmen Leitch
SEP 30, 2021
Microbiology
When health officials are trying to control a disease outbreak, diagnostic tests can be a crucial tool that provides inf
...
Written By:
Carmen Leitch
SEP 30, 2021
Clinical & Molecular DX
Schematic illustration of the adhesive patch with diving beetle–inspired suction chambers against rough and wet hu
...
Written By:
Tara Fernandes
SEP 30, 2021
Clinical & Molecular DX
At nine months old, most babies have started moving around independently and are curiously exploring the exciting new wo
...
Written By:
Tara Fernandes